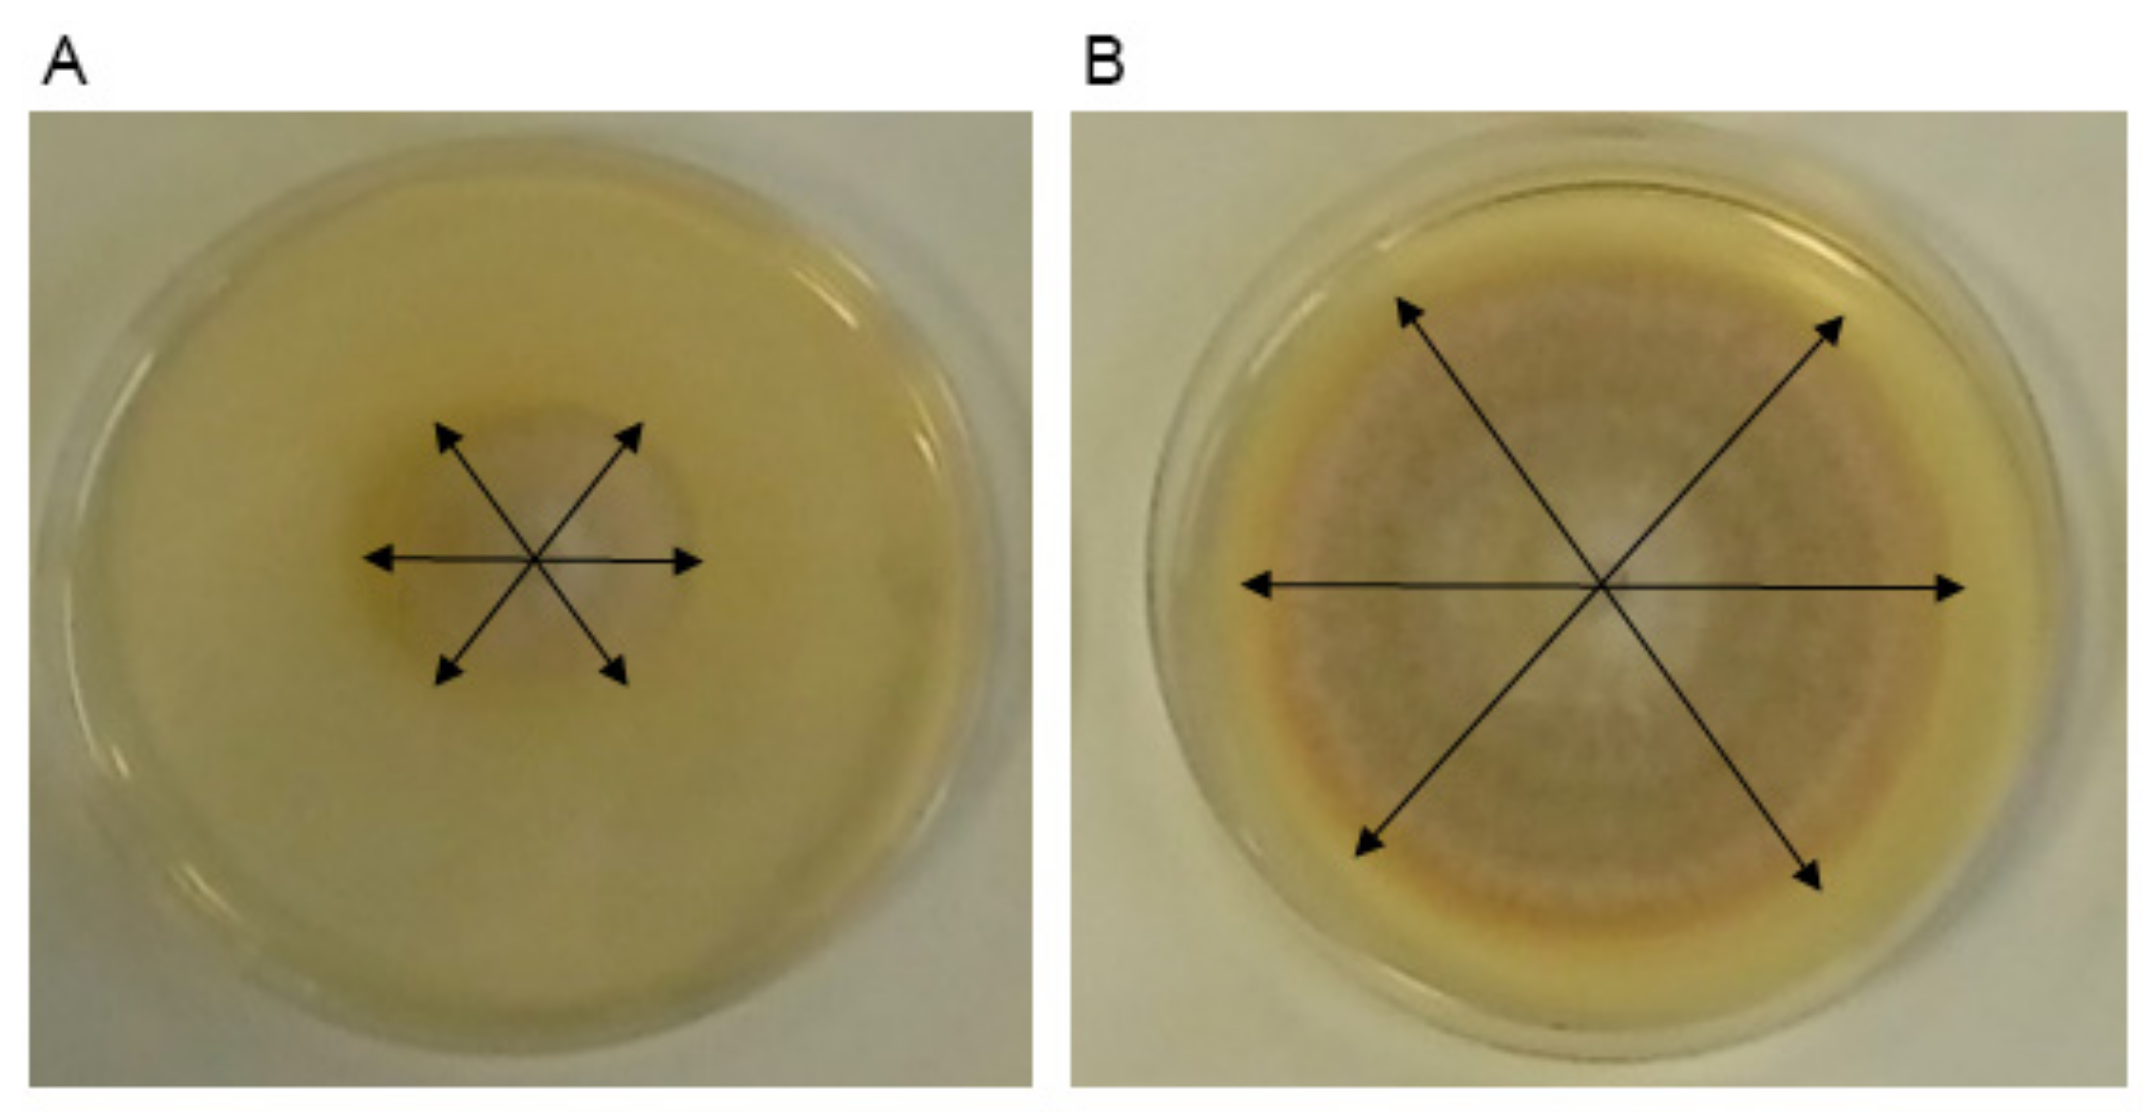
Jof 07 00248 g002

Volatile Organic Compound Chamber: A Novel Technology for Microbiological Volatile Interaction Assays
Abstract
1. Introduction
2. Materials and Methods
2.1. VOC Chamber: General Technical Description
2.2. VOC Chamber: Prototypes
2.3. Microbial Strains and Culture Conditions
2.4. In Vitro Evaluation of VOC-Mediated Interactions between R. solani R43 and Trichoderma Using DDS Method, Vented, and Non-Vented VOC Chambers
2.5. In Vitro Evaluation of VOC-Mediated Interactions between F. oxysporum F3 and Trichoderma Using the DDS Method, Vented, and Non-Vented VOC Chambers
2.6. Data Treatment and Statistical Analysis
3. Results
3.1. Homogeneity and Replicability of the Results
3.2. Volatile Activity of Trichoderma Against R. solani R43 and F. oxysporum F3. Statistical Differences in Growth Results Using the DDS Method, Non-Vented, and Vented VOC Chambers
3.3. Volatile Activity of Trichoderma Against R. solani R43 and F. oxysporum F3. Quantitative and Qualitative Differences in Percentage of Inhibition (PI) Using the DDS Method, Non-Vented, and Vented VOC Chambers
3.4. Effects of erg1 Silencing and T. arundinaceum tri5 Expression on the Volatile Activity of T. harzianum T34 against R. solani R43 and F. oxysporum F3
3.5. Additional Effects Produced by the Used of DDS, Non-Vented and Vented VOC Chambers
4. Discussion
4.1. Differences in Selectivity and Homogeneity Between Methods
4.2. Quantitative and Qualitative Effects of Different Ventilation Conditions
4.3. Effects of the erg1 Silencing and tri5 Expression
4.4. Additional Observations and Final Overview
5. Patents
Supplementary Materials
Author Contributions
Funding
Institutional Review Board Statement
Informed Consent Statement
Data Availability Statement
Acknowledgments
Conflicts of Interest
References
- Effmert, U.; Kalderás, J.; Warnke, R.; Piechulla, B. Volatile mediated interactions between bacteria and fungi in the soil. J. Chem. Ecol. 2012, 38, 665–703. [Google Scholar] [CrossRef] [PubMed]
- Li, X.; Garbeva, P.; Liu, X.; klein Gunnewiek, P.J.A.; Clocchiatti, A.; Hundscheid, M.P.J.; Wang, X.; de Boer, W. Volatile-mediated antagonism of soil bacterial communities against fungi. Environ. Microbiol. 2020, 22, 1025–1035. [Google Scholar] [CrossRef]
- Gershow, M.; Berck, M.; Mathew, D.; Luo, L.; Kane, E.A.; Carlson, J.R.; Samuel, A.D.T. Controlling airborne cues to study small animal navigation. Nat. Methods 2012, 9, 290–296. [Google Scholar] [CrossRef] [PubMed]
- Rodríguez-González, Á.; Casquero, P.A.; Suárez-Villanueva, V.; Carro-Huerga, G.; Álvarez-García, S.; Mayo-Prieto, S.; Lorenzana, A.; Cardoza, R.E.; Gutiérrez, S. Effect of trichodiene production by Trichoderma harzianum on Acanthoscelides obtectus. J. Stored Prod. Res. 2018, 77, 231–239. [Google Scholar] [CrossRef]
- Dudareva, N.; Pichersky, E. Metabolic engineering of plant volatiles. Curr. Opin. Biotechnol. 2008, 19, 181–189. [Google Scholar] [CrossRef]
- Heil, M.; Karban, R. Explaining evolution of plant communication by airborne signals. Trends Ecol. Evol. 2010, 25, 137–144. [Google Scholar] [CrossRef] [PubMed]
- Quintana-Rodriguez, E.; Morales-Vargas, A.T.; Molina-Torres, J.; Ádame-Alvarez, R.M.; Acosta-Gallegos, J.A.; Heil, M. Plant volatiles cause direct, induced and associational resistance in common bean to the fungal pathogen Colletotrichum lindemuthianum. J. Ecol. 2015, 103, 250–260. [Google Scholar] [CrossRef]
- Moisan, K.; Cordovez, V.; van de Zande, E.M.; Raaijmakers, J.M.; Dicke, M.; Lucas-Barbosa, D. Volatiles of pathogenic and non-pathogenic soil-borne fungi affect plant development and resistance to insects. Oecologia 2019, 190, 589–604. [Google Scholar] [CrossRef]
- Kai, M.; Effmert, U.; Piechulla, B. Bacterial-plant-interactions: Approaches to unravel the biological function of bacterial volatiles in the rhizosphere. Front. Microbiol. 2016, 7. [Google Scholar] [CrossRef]
- Scott, J.; Sueiro-Olivares, M.; Ahmed, W.; Heddergott, C.; Zhao, C.; Thomas, R.; Bromley, M.; Latgé, J.P.; Krappmann, S.; Fowler, S.; et al. Pseudomonas aeruginosa-derived volatile sulfur compounds promote distal Aspergillus fumigatus growth and a synergistic pathogen-pathogen interaction that increases pathogenicity in co-infection. Front. Microbiol. 2019, 10, 1–15. [Google Scholar] [CrossRef]
- Giorgio, A.; De Stradis, A.; Lo Cantore, P.; Iacobellis, N.S. Biocide effects of volatile organic compounds produced by potential biocontrol rhizobacteria on Sclerotinia sclerotiorum. Front. Microbiol. 2015, 6, 1056. [Google Scholar] [CrossRef] [PubMed]
- Loulier, J.; Lefort, F.; Stocki, M.; Asztemborska, M.; Szmigielski, R.; Siwek, K.; Grzywacz, T.; Hsiang, T.; Ślusarski, S.; Oszako, T.; et al. Detection of fungi and Oomycetes by volatiles using E-Nose and SPME-GC/MS platforms. Molecules 2020, 25, 5749. [Google Scholar] [CrossRef]
- Borowik, P.; Adamowicz, L.; Tarakowski, R.; Wacławik, P.; Oszako, T.; Ślusarski, S.; Tkaczyk, M. Application of a low-cost Electronic Nose for differentiation between pathogenic Oomycetes Pythium intermedium and Phytophthora plurivora. Sensors 2021, 21, 1326. [Google Scholar] [CrossRef] [PubMed]
- Tilocca, B.; Cao, A.; Migheli, Q. Scent of a killer: Microbial volatilome and its role in the biological control of plant pathogens. Front. Microbiol. 2020, 11. [Google Scholar] [CrossRef]
- Dukare, A.S.; Paul, S.; Nambi, V.E.; Gupta, R.K.; Singh, R.; Sharma, K.; Vishwakarma, R.K. Exploitation of microbial antagonists for the control of postharvest diseases of fruits: A review. Crit. Rev. Food Sci. Nutr. 2019, 59, 1498–1513. [Google Scholar] [CrossRef] [PubMed]
- Avalos, M.; van Wezel, G.P.; Raaijmakers, J.M.; Garbeva, P. Healthy scents: Microbial volatiles as new frontier in antibiotic research? Curr. Opin. Microbiol. 2018, 45, 84–91. [Google Scholar] [CrossRef] [PubMed]
- Schulz-Bohm, K.; Geisen, S.; Wubs, E.R.J.; Song, C.; De Boer, W.; Garbeva, P. The prey’s scent—Volatile organic compound mediated interactions between soil bacteria and their protist predators. ISME J. 2017, 11, 817–820. [Google Scholar] [CrossRef] [PubMed]
- Massalha, H.; Korenblum, E.; Tholl, D.; Aharoni, A. Small molecules below-ground: The role of specialized metabolites in the rhizosphere. Plant J. 2017, 90, 788–807. [Google Scholar] [CrossRef] [PubMed]
- Wenke, K.; Kopka, J.; Schwachtje, J.; van Dongen, J.T.; Piechulla, B. Volatiles of rhizobacteria Serratia and Stenotrophomonas alter growth and metabolite composition of Arabidopsis thaliana. Plant Biol. 2019, 21, 109–119. [Google Scholar] [CrossRef]
- Hung, R.; Lee, S.; Bennett, J.W. Arabidopsis thaliana as a model system for testing the effect of Trichoderma volatile organic compounds. Fungal Ecol. 2013, 6, 19–26. [Google Scholar] [CrossRef]
- Ditengou, F.A.; Müller, A.; Rosenkranz, M.; Felten, J.; Lasok, H.; van Doorn, M.M.; Legué, V.; Palme, K.; Schnitzler, J.-P.; Polle, A. Volatile signalling by sesquiterpenes from ectomycorrhizal fungi reprogrammes root architecture. Nat. Commun. 2015, 6, 6279. [Google Scholar] [CrossRef]
- Malmierca, M.G.; Mccormick, S.P.; Cardoza, R.E.; Alexander, N.J.; Monte, E.; Gutiérrez, S. Production of trichodiene by Trichoderma harzianum alters the perception of this biocontrol strain by plants and antagonized fungi. Environ. Microbiol. 2015, 17, 2628–2646. [Google Scholar] [CrossRef] [PubMed]
- Schenkel, D.; Maciá-Vicente, J.G.; Bissell, A.; Splivallo, R. Fungi indirectly affect plant root architecture by modulating soil volatile organic compounds. Front. Microbiol. 2018, 9, 1–13. [Google Scholar] [CrossRef]
- Cordovez, V.; Mommer, L.; Moisan, K.; Lucas-Barbosa, D.; Pierik, R.; Mumm, R.; Carrion, V.J.; Raaijmakers, J.M. Plant phenotypic and transcriptional changes induced by volatiles from the fungal root pathogen Rhizoctonia solani. Front. Plant Sci. 2017, 8. [Google Scholar] [CrossRef] [PubMed]
- Korpi, A.; Järnberg, J.; Pasanen, A.L. Microbial volatile organic compounds. Crit. Rev. Toxicol. 2009, 39, 139–193. [Google Scholar] [CrossRef]
- Ortíz-Castro, R.; Contreras-Cornejo, H.A.; Macías-Rodríguez, L.; López-Bucio, J. The role of microbial signals in plant growth and development. Plant Signal. Behav. 2009, 4, 701–712. [Google Scholar] [CrossRef]
- Oszako, T.; Voitka, D.; Stocki, M.; Stocka, N.; Nowakowska, J.A.; Linkiewicz, A.; Hsiang, T.; Belbahri, L.; Berezovska, D.; Malewski, T. Trichoderma asperellum efficiently protects Quercus robur leaves against Erysiphe alphitoides. Eur. J. Plant Pathol. 2021, 159, 295–308. [Google Scholar] [CrossRef]
- Kottb, M.; Gigolashvili, T.; Großkinsky, D.K.; Piechulla, B. Trichoderma volatiles effecting Arabidopsis: From inhibition to protection against phytopathogenic fungi. Front. Microbiol. 2015, 6. [Google Scholar] [CrossRef] [PubMed]
- Li, N.; Alfiky, A.; Wang, W.; Islam, M.; Nourollahi, K.; Liu, X.; Kang, S. Volatile compound-mediated recognition and inhibition between Trichoderma biocontrol agents and Fusarium oxysporum. Front. Microbiol. 2018, 9, 1–16. [Google Scholar] [CrossRef] [PubMed]
- Speckbacher, V.; Ruzsanyi, V.; Wigger, M.; Zeilinger, S. The Trichoderma atroviride strains P1 and IMI 206040 differ in their light-response and VOC production. Molecules 2020, 25. [Google Scholar] [CrossRef] [PubMed]
- Dennis, C.; Webster, J. Antagonistic properties of species-groups of Trichoderma. II Production of volatile antibiotics. Trans. Br. Mycol. Soc. 1971, 57, 41–48. [Google Scholar] [CrossRef]
- Alijani, Z.; Amini, J.; Ashengroph, M.; Bahramnejad, B. Antifungal activity of volatile compounds produced by Staphylococcus sciuri strain MarR44 and its potential for the biocontrol of Colletotrichum nymphaeae, causal agent strawberry anthracnose. Int. J. Food Microbiol. 2019, 307. [Google Scholar] [CrossRef]
- Noguchi, Y.; Shimba, N.; Toyosaki, H.; Ebisawa, K.; Kawahara, Y.; Suzuki, E.I.; Sugimoto, S. In vivo NMR system for evaluating oxygen-dependent metabolic status in microbial culture. J. Microbiol. Methods 2002, 51, 73–82. [Google Scholar] [CrossRef]
- Spadaro, D.; Droby, S. Development of biocontrol products for postharvest diseases of fruit: The importance of elucidating the mechanisms of action of yeast antagonists. Trends Food Sci. Technol. 2016, 47, 39–49. [Google Scholar] [CrossRef]
- Morath, S.U.; Hung, R.; Bennett, J.W. Fungal volatile organic compounds: A review with emphasis on their biotechnological potential. Fungal Biol. Rev. 2012, 26, 73–83. [Google Scholar] [CrossRef]
- Lo Cantore, P.; Giorgio, A.; Iacobellis, N.S. Bioactivity of volatile organic compounds produced by Pseudomonas tolaasii. Front. Microbiol. 2015, 6, 1–14. [Google Scholar] [CrossRef]
- El-Hasan, A.; Schöne, J.; Höglinger, B.; Walker, F.; Voegele, R.T. Assessment of the antifungal activity of selected biocontrol agents and their secondary metabolites against Fusarium graminearum. Eur. J. Plant Pathol. 2018, 150, 91–103. [Google Scholar] [CrossRef]
- El Ariebi, N.; Hiscox, J.; Scriven, S.A.; Müller, C.T.; Boddy, L. Production and effects of volatile organic compounds during interspecific interactions. Fungal Ecol. 2016, 20, 144–154. [Google Scholar] [CrossRef]
- Inamdar, A.A.; Zaman, T.; Morath, S.U.; Pu, D.C.; Bennett, J.W. Drosophila melanogaster as a model to characterize fungal volatile organic compounds. Environ. Toxicol. 2014, 29, 829–836. [Google Scholar] [CrossRef] [PubMed]
- Cernava, T.; Aschenbrenner, I.A.; Grube, M.; Liebminger, S.; Berg, G. A novel assay for the detection of bioactive volatiles evaluated by screening of lichen-associated bacteria. Front. Microbiol. 2015, 6. [Google Scholar] [CrossRef]
- Cardoza, R.E.; Vizcaíno, J.A.; Hermosa, M.R.; Sousa, S.; González, F.J.; Llobell, A.; Monte, E.; Gutiérrez, S. Cloning and characterization of the erg1 gene of Cursiva: Trichoderma harzianum: Effect of the erg1 silencing on ergosterol biosynthesis and resistance to terbinafine. Fungal Genet. Biol. 2006, 43, 164–178. [Google Scholar] [CrossRef] [PubMed]
- Cardoza, R.E.; McCormick, S.P.; Malmierca, M.G.; Olivera, E.R.; Alexander, N.J.; Monte, E.; Gutiérrez, S. Effects of trichothecene production on the plant defense response and fungal physiology: Overexpression of the Trichoderma arundinaceum tri4 gene in T. harzianum. Appl. Environ. Microbiol. 2015, 81, 6355–6366. [Google Scholar] [CrossRef]
- Malmierca, M.G.; McCormick, S.P.; Cardoza, R.E.; Monte, E.; Alexander, N.J.; Gutiérrez, S. Trichodiene production in a Trichoderma harzianum erg1-silenced strain provides evidence of the importance of the sterol biosynthetic pathway in inducing plant defense-related gene expression. Mol. Plant. Microbe. Interact. 2015, 28, 1181–1197. [Google Scholar] [CrossRef]
- Mayo, S.; Gutiérrez, S.; Malmierca, M.G.; Lorenzana, A.; Campelo, M.P.; Hermosa, R.; Casquero, P.A. Influence of Rhizoctonia solani and Trichoderma spp. in growth of bean (Phaseolus vulgaris L.) and in the induction of plant defense-related genes. Front. Plant Sci. 2015, 6. [Google Scholar] [CrossRef] [PubMed]
- Mutawila, C.; Vinale, F.; Halleen, F.; Lorito, M.; Mostert, L. Isolation, production and in vitro effects of the major secondary metabolite produced by Trichoderma species used for the control of grapevine trunk diseases. Plant Pathol. 2016, 65, 104–113. [Google Scholar] [CrossRef]
- Gotor-Vila, A.; Teixidó, N.; Di Francesco, A.; Usall, J.; Ugolini, L.; Torres, R.; Mari, M. Antifungal effect of volatile organic compounds produced by Bacillus amyloliquefaciens CPA-8 against fruit pathogen decays of cherry. Food Microbiol. 2017, 64, 219–225. [Google Scholar] [CrossRef] [PubMed]
- Myo, E.M.; Liu, B.; Ma, J.; Shi, L.; Jiang, M.; Zhang, K.; Ge, B. Evaluation of Bacillus velezensis NKG-2 for bio-control activities against fungal diseases and potential plant growth promotion. Biol. Control 2019, 134, 23–31. [Google Scholar] [CrossRef]
- Mulero-Aparicio, A.; Cernava, T.; Turrà, D.; Schaefer, A.; Di Pietro, A.; López-Escudero, F.J.; Trapero, A.; Berg, G. The role of volatile organic compounds and rhizosphere competence in mode of action of the non-pathogenic Fusarium oxysporum fo12 toward verticillium wilt. Front. Microbiol. 2019, 10. [Google Scholar] [CrossRef]
- Schmidt, R.; De Jager, V.; Zühlke, D.; Wolff, C.; Bernhardt, J.; Cankar, K.; Beekwilder, J.; Van Ijcken, W.; Sleutels, F.; De Boer, W.; et al. Fungal volatile compounds induce production of the secondary metabolite Sodorifen in Serratia plymuthica PRI-2C. Sci. Rep. 2017, 7. [Google Scholar] [CrossRef] [PubMed]
- Di Francesco, A.; Martini, C.; Mari, M. Biological control of postharvest diseases by microbial antagonists: How many mechanisms of action? Eur. J. Plant Pathol. 2016, 145, 1498–1513. [Google Scholar] [CrossRef]
- Kashyap, P.L.; Solanki, M.K.; Kushwaha, P.; Kumar, S.; Srivastava, A.K. Biocontrol potential of salt-tolerant Trichoderma and Hypocrea isolates for the management of tomato root rot under saline environment. J. Soil Sci. Plant Nutr. 2020, 20, 160–176. [Google Scholar] [CrossRef]
- Kai, M.; Effmert, U.; Berg, G.; Piechulla, B. Volatiles of bacterial antagonists inhibit mycelial growth of the plant pathogen Rhizoctonia solani. Arch. Microbiol. 2007, 187, 351–360. [Google Scholar] [CrossRef]
- Baker, R.A.; Tatum, J.H.; Nemec, S. Antimicrobial activity of naphthoquinones from Fusaria. Mycopathologia 1990, 111, 9–15. [Google Scholar] [CrossRef]
- Medentsev, A.G.; Akimenko, V.K. Naphthoquinone of the Fungi. Phytochemistry 1998, 47, 935–959. [Google Scholar] [CrossRef]
- Taylor, L.; Gutierrez, S.; McCormick, S.P.; Bakker, M.G.; Proctor, R.H.; Teresi, J.; Kurtzman, B.; Hao, G.; Vaughan, M.M. Use of the volatile trichodiene to reduce Fusarium head blight and trichothecene contamination in wheat. Microb. Biotechnol. 2021. [Google Scholar] [CrossRef] [PubMed]
- Clark, G.J.; Langley, D.; Bushell, M.E. Oxygen limitation can induce microbial secondary metabolite formation: Investigations with miniature electrodes in shaker and bioreactor culture. Microbiology 1995, 141, 663–669. [Google Scholar] [CrossRef]
- Kim, Y.T.; Monkhung, S.; Lee, Y.S.; Kim, K.Y. Effects of Lysobacter antibioticus hs124, an effective biocontrol agent against Fusarium graminearum, on crown rot disease and growth promotion of wheat. Can. J. Microbiol. 2019, 65, 904–912. [Google Scholar] [CrossRef] [PubMed]
- Arrarte, E.; Garmendia, G.; Rossini, C.; Wisniewski, M.; Vero, S. Volatile organic compounds produced by Antarctic strains of Candida sake play a role in the control of postharvest pathogens of apples. Biol. Control 2017, 109, 14–20. [Google Scholar] [CrossRef]
- Elkahoui, S.; Djébali, N.; Yaich, N.; Azaiez, S.; Hammami, M.; Essid, R.; Limam, F. Antifungal activity of volatile compounds-producing Pseudomonas P2 strain against Rhizoctonia solani. World J. Microbiol. Biotechnol. 2015, 31, 175–185. [Google Scholar] [CrossRef]
- Scarselletti, R.; Faull, J.L. In vitro activity of 6-pentyl-α-pyrone, a metabolite of Trichoderma harzianum, in the inhibition of Rhizoctonia solani and Fusarium oxysporum f. sp. lycopersici. Mycol. Res. 1994, 98, 1207–1209. [Google Scholar] [CrossRef]
- Siddiquee, S.; Cheong, B.E.; Taslima, K.; Kausar, H.; Hasan, M.M. Separation and identification of volatile compounds from liquid cultures of Trichoderma harzianum by GC-MS using three different capillary columns. J. Chromatogr. Sci. 2012, 50, 358–367. [Google Scholar] [CrossRef]
- Halifu, S.; Deng, X.; Song, X.; Song, R.; Liang, X. Inhibitory mechanism of Trichoderma virens ZT05 on Rhizoctonia solani. Plants 2020, 9, 1–18. [Google Scholar] [CrossRef]
- Strobel, G.A.; Spang, S.; Kluck, K.; Hess, W.M.; Sears, J.; Livinghouse, T. Synergism among volatile organic compounds resulting in increased antibiosis in Oidium sp. FEMS Microbiol. Lett. 2008, 283, 140–145. [Google Scholar] [CrossRef] [PubMed]

| Coefficient of Variation R43 Experiment 1 | ||||
|---|---|---|---|---|
| Method | Mean | SD | SE | Statistics |
| DDS | 0.156 | 0.083 | 0.019 | A |
| Non-vented | 0.048 | 0.024 | 0.005 | B |
| Vented | 0.057 | 0.040 | 0.009 | B |
| Coefficient of Variation R43 Experiment 2 | ||||
| Method | Mean | SD | SE | Statistics |
| DDS | 0.10 | 0.056 | 0.012 | A |
| Non-vented | 0.040 | 0.016 | 0.004 | B |
| Vented | 0.069 | 0.039 | 0.009 | B |
| Coefficient of Variation F3 Experiment 1 | ||||
| Method | Mean | SD | SE | Statistics |
| DDS | 0.062 | 0.037 | 0.010 | A |
| Non-vented | 0.035 | 0.027 | 0.007 | B |
| Vented | 0.026 | 0.014 | 0.004 | B |
| Coefficient of Variation F3 Experiment 2 | ||||
| Method | Mean | SD | SE | Statistics |
| DDS | 0.050 | 0.015 | 0.004 | A |
| Non-vented | 0.021 | 0.008 | 0.002 | B |
| Vented | 0.031 | 0.015 | 0.004 | B |
Publisher’s Note: MDPI stays neutral with regard to jurisdictional claims in published maps and institutional affiliations. |
© 2021 by the authors. Licensee MDPI, Basel, Switzerland. This article is an open access article distributed under the terms and conditions of the Creative Commons Attribution (CC BY) license (http://creativecommons.org/licenses/by/4.0/).
Share and Cite
Álvarez-García, S.; Mayo-Prieto, S.; Carro-Huerga, G.; Rodríguez-González, Á.; González-López, Ó.; Gutiérrez, S.; Casquero, P.A. Volatile Organic Compound Chamber: A Novel Technology for Microbiological Volatile Interaction Assays. J. Fungi 2021, 7, 248. https://doi.org/10.3390/jof7040248
Álvarez-García S, Mayo-Prieto S, Carro-Huerga G, Rodríguez-González Á, González-López Ó, Gutiérrez S, Casquero PA. Volatile Organic Compound Chamber: A Novel Technology for Microbiological Volatile Interaction Assays. Journal of Fungi. 2021; 7(4):248. https://doi.org/10.3390/jof7040248
Chicago/Turabian StyleÁlvarez-García, Samuel, Sara Mayo-Prieto, Guzmán Carro-Huerga, Álvaro Rodríguez-González, Óscar González-López, Santiago Gutiérrez, and Pedro A. Casquero. 2021. "Volatile Organic Compound Chamber: A Novel Technology for Microbiological Volatile Interaction Assays" Journal of Fungi 7, no. 4: 248. https://doi.org/10.3390/jof7040248
APA StyleÁlvarez-García, S., Mayo-Prieto, S., Carro-Huerga, G., Rodríguez-González, Á., González-López, Ó., Gutiérrez, S., & Casquero, P. A. (2021). Volatile Organic Compound Chamber: A Novel Technology for Microbiological Volatile Interaction Assays. Journal of Fungi, 7(4), 248. https://doi.org/10.3390/jof7040248

